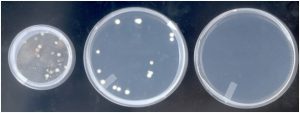

Cos’è ABIOS®?
ABIOS® è il macchinario progettato e brevettato da RGI che permette di prevenire i danni causati dalla proliferazione di batteri, funghi e microrganismi alle opere d’arte: aspira l’aria presente nell’ambiente, la sterlizza e la reimmette in atmosfera priva di microorganismi.
Prevenzione della proliferazione batterica nelle opere d’arte
Il progetto ABIOS®(Aerosol Biological Sterilizer) nasce dalla necessità di prevenire e proteggere le collezioni conservate nei musei, biblioteche e archivi dalle minacce di natura biologica senza fare ricorso a sostanze chimiche, pericolose per la salute delle opere d’arte e delle persone.
La ricerca condotta tra il 2005 e il 2007 nell’ambito del Progetto Europeo Cordis, ha coinvolto l’Università di Roma, – Dipartimento di Fitopatologia, il NILU Institut (Norvegia), Mycoteam (Norvegia), AMOS (Belgio) e il Museo Nazionale di Cracovia (Polonia). Negli anni successivi sono state apportate ulteriori innovazioni che hanno perfezionato l’efficacia dei macchinari contro virus e batteri presenti in atmosfera.


Sterilizzazione e riconversione dell’ozono in ossigeno
La tecnologia impiegata da Abios® si basa sull’applicazione di radiazioni UV a onde corte, in grado di eliminare i microrganismi sospesi in aria sotto forma di bio-aerosol. La geometria fluido dinamica e la particolare progettazione di Abios® impediscono l’irradiazione dei raggi UV sull’ambiente circostante.
Quando l’aria viene colpita dalle radiazioni ultraviolette, parte dell’ossigeno viene trasformato in ozono, un gas molto dannoso per l’uomo, se superiore alla concentrazione di 0,10 ppm.
Il filtro catalizzatore di Abios permette di risolvere alla radice il problema della permanenza di tracce residue di ozono, attraverso la riconversione in ossigeno.
I risultati dei test di laboratorio con ABIOS®
I test effettuati presso il laboratorio di Microbiologia dell’Università di Roma La Sapienza hanno dimostrato una diminuzione di attività microbica dell’aria del 99,98% in 12 ore, all’interno di una sala prove di 40 m3.
I dati raccolti hanno evidenziato che i benefici della sterilizzazione dell’aria riguardano tutta la gamma dei batteri e microbi nocivi per l’uomo: un risultato straordinario che consente di garantire salute e benessere agli operatori del settore museale e agli utilizzatori di biblioteche, archivi, emeroteche.
Le immagini sono relative a campioni raccolti all’interno di una camera sperimentale di 40 mc, contaminata artificialmente: il primo è stato raccolto prima di installare ABIOS®, la seconda dopo 6 ore dalla sua attivazione e il terzo dopo 12 ore.
Le condizioni ideali per la massima efficacia
ABIOS elimina virus e batteri dall’aria in ambienti chiusi e confinati: i risultati dei test effettuati dimostrano che l’efficacia massima della sterilizzazione si ottiene in una camera di laboratorio sigillata.
Abios®aspira l’aria ambientale e la filtra più ripetutamente, abbattendo progressivamente la carica virale e batterica.
Tre sono i fattori principali che incidono sul raggiungimento della massima efficacia di Abios®:
1) Il livello di “chiusura” dell’ambiente di installazione (numero di finestre, porte, accessi orari, quantità di persone presenti nello stesso momento)
2) Il volume dell’ambiente rispetto al numero di unità Abios® installate: Abios® si adatta anche a ambienti molto grandi e la sua natura modulare permette di impiegare più unità in caso di ambienti grandi o molto frequentati
3) Il livello di infestazione degli ambienti:
Abios® elimina il 99,9% di microorganismi in 24 ore; più unità virali/batteriche vengono immesse nell’ambiente, più ne verrà influenzata l’efficacia. È possibile mantenere lo stesso livello di efficacia con l’installazione di più unità nello stesso ambiente.


Caratteristiche di ABIOS®
- Prevenzione dei danni alle opere d’arte
- Prevenzione dei danni alla salute di operatori e visitatori di musei e biblioteche
- Facilità d’uso
- Flusso d’aria regolabile
- Costo contenuto, affidabilità e durata nel tempo
- Minima manutenzione
- Installazione rapida in ogni tipo di ambiente grazie a peso e dimensione ridotti
- Funzionamento continuo
